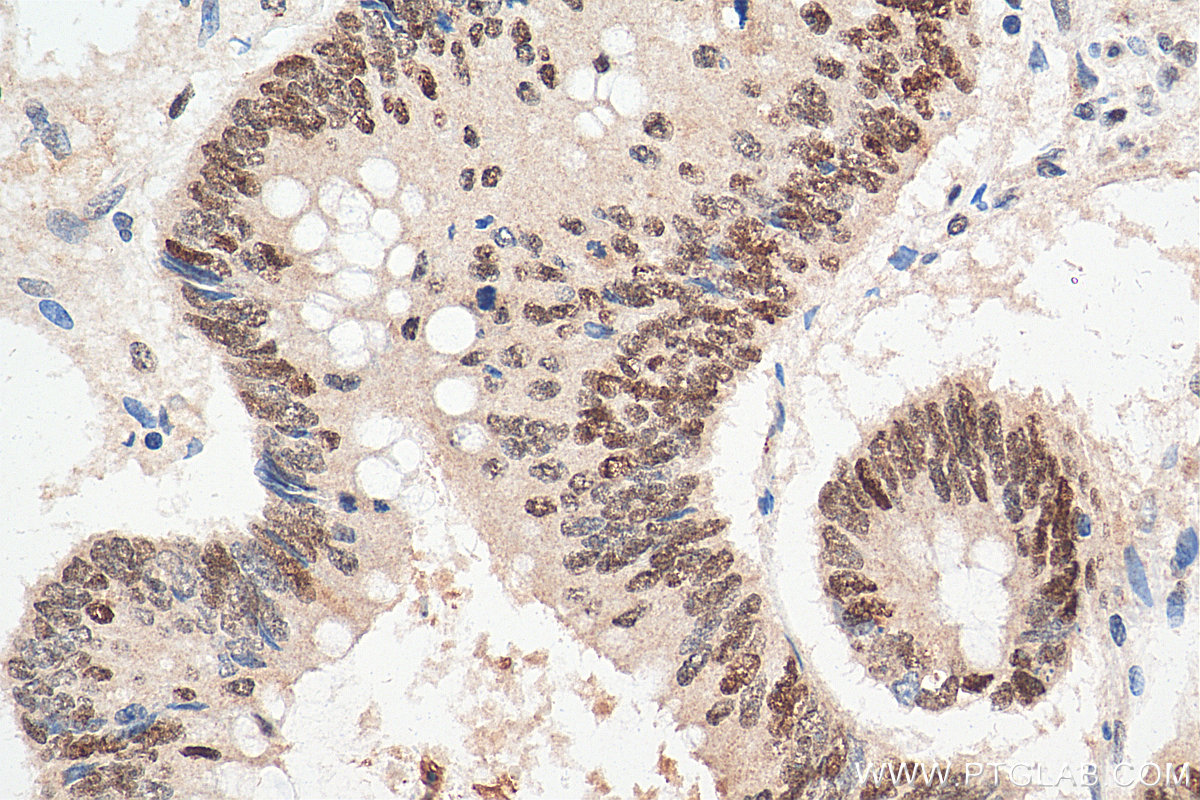

验证数据展示
经过测试的应用
| Positive WB detected in | K-562 cells, mouse placenta tissue |
| Positive IP detected in | K-562 cells |
| Positive IHC detected in | human colon cancer tissue Note: suggested antigen retrieval with TE buffer pH 9.0; (*) Alternatively, antigen retrieval may be performed with citrate buffer pH 6.0 |
| Positive IF/ICC detected in | HepG2 cells |
推荐稀释比
| 应用 | 推荐稀释比 |
|---|---|
| Western Blot (WB) | WB : 1:500-1:2000 |
| Immunoprecipitation (IP) | IP : 0.5-4.0 ug for 1.0-3.0 mg of total protein lysate |
| Immunohistochemistry (IHC) | IHC : 1:300-1:1200 |
| Immunofluorescence (IF)/ICC | IF/ICC : 1:50-1:500 |
| It is recommended that this reagent should be titrated in each testing system to obtain optimal results. | |
| Sample-dependent, Check data in validation data gallery. | |
产品信息
14068-1-AP targets ARID3A in WB, IHC, IF/ICC, IP, ChIP, ELISA applications and shows reactivity with human, mouse samples.
| 经测试应用 | WB, IHC, IF/ICC, IP, ELISA Application Description |
| 文献引用应用 | WB, IHC, IF, IP, ChIP |
| 经测试反应性 | human, mouse |
| 文献引用反应性 | human, mouse |
| 免疫原 |
CatNo: Ag5124 Product name: Recombinant human ARID3A protein Source: e coli.-derived, PGEX-4T Tag: GST Domain: 244-593 aa of BC060828 Sequence: FLDDLFSFMQKRGTPVNRIPIMAKQVLDLFMLYVLVTEKGGLVEVINKKLWREITKGLNLPTSITSAAFTLRTQYMEYLYPYECEKRGLSNPNELQAAIDSNRREGRRQSFGGSLFAYSPGGAHGMLSSPKLPVSSLGLAASTNGSSITPAPKIKKEEDSAIPITVPGRLPVSLAGHPVVAAQAAAVQAAAAQAAVAAQAAALEQLREKLESAEPPEKKMALVADEQQRLMQRALQQNFLAMAAQLPMSIRINSQASESRQDSAVNLTGTNGSNSISMSVEINGIMYTGVLFAQPPAPTPTSAPNKGGGGGGSSSSNAGGRGGNTGTSGGQAGPAGLSTPSTSTSNNSLP 种属同源性预测 |
| 宿主/亚型 | Rabbit / IgG |
| 抗体类别 | Polyclonal |
| 产品类型 | Antibody |
| 全称 | AT rich interactive domain 3A (BRIGHT-like) |
| 别名 | DRIL1, Dead ringer-like protein 1, BRIGHT, B-cell regulator of IgH transcription, AT-rich interactive domain-containing protein 3A |
| 计算分子量 | 63 kDa |
| 观测分子量 | 75 kDa |
| GenBank蛋白编号 | BC060828 |
| 基因名称 | ARID3A |
| Gene ID (NCBI) | 1820 |
| RRID | AB_2060390 |
| 偶联类型 | Unconjugated |
| 形式 | Liquid |
| 纯化方式 | Antigen affinity purification |
| UNIPROT ID | Q99856 |
| 储存缓冲液 | PBS with 0.02% sodium azide and 50% glycerol, pH 7.3. |
| 储存条件 | Store at -20°C. Stable for one year after shipment. Aliquoting is unnecessary for -20oC storage. |
背景介绍
ARID3A is a nuclear matrix-associated transcription factor that stimulates immunoglobulin heavy chain (IgH) expression and Cyclin E1/E2F-dependent cell cycle progression. It activates IgH transcriptional initiation by binding to ATC-rich P sites within nuclear matrix attachment regions (MARs) flanking the IgH intronic enhancer (Emu) (PMID:17386101). It is the founder of the 13-member (in humans) ARID (AT-Rich Interaction Domain) family, which share a highly conserved DNA binding domain, but functions in diverse biological processes such as cell cycle regulated events, epigenetic post-translational modification, and chromatin remodeling (PMID:15927959,11959810,11283269). The expression molecular weight observed is consistent with what has been described in the literature (PMID: 15922553, 19436740).
实验方案
| Product Specific Protocols | |
|---|---|
| IF protocol for ARID3A antibody 14068-1-AP | Download protocol |
| IHC protocol for ARID3A antibody 14068-1-AP | Download protocol |
| IP protocol for ARID3A antibody 14068-1-AP | Download protocol |
| WB protocol for ARID3A antibody 14068-1-AP | Download protocol |
| Standard Protocols | |
|---|---|
| Click here to view our Standard Protocols |
发表文章
| Species | Application | Title |
|---|---|---|
Cell Rep Med Personalized drug screening in patient-derived organoids of biliary tract cancer and its clinical application | ||
PLoS Genet Let-7 Represses Carcinogenesis and a Stem Cell Phenotype in the Intestine via Regulation of Hmga2. | ||
FASEB J Exosomal let-7b-5p deriving from parietal epithelial cells attenuate renal fibrosis through suppression of TGFβR1 and ARID3a in obstructive kidney disease | ||
Carcinogenesis ARID3A promotes the development of colorectal cancer by upregulating AURKA.
| ||
Ann Surg Oncol High Expression of AT-Rich Interactive Domain 3A (ARID3A) is Associated with Good Prognosis in Colorectal Carcinoma. | ||
Cell Biol Int ARID3A plays a key regulatory role in palmitic acid-stimulated milk fat synthesis in mouse mammary epithelial cells
|